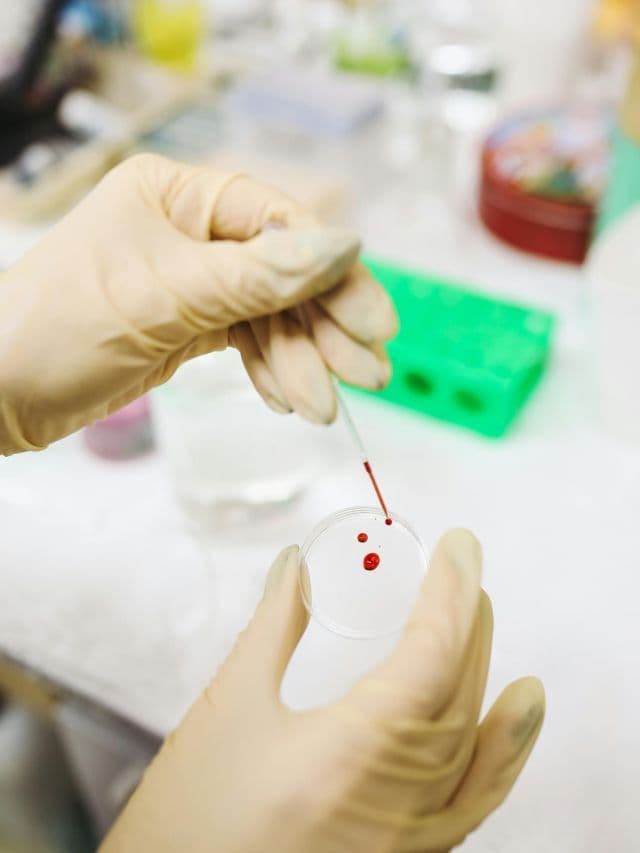

Vírus Sob Controle
Pesquisa inovadora sobre partículas imunomoduladoras. Entenda como uma cientista está revolucionando o combate a doenças. Descubra os detalhes

A pesquisa sobre partículas imunomoduladoras tem sido um tema de grande interesse na comunidade científica, especialmente quando se trata de combater doenças causadas por vírus. Uma cientista brasileira tem se destacado nessa área, desenvolvendo estudos inovadores que visam entender como essas partículas podem ser utilizadas para controlar e prevenir a propagação de vírus.
A abordagem dessa cientista é única, pois ela busca entender como as partículas imunomoduladoras podem ser utilizadas para fortalecer o sistema imunológico e prevenir a infecção por vírus. Seu trabalho tem o potencial de revolucionar o tratamento de doenças virais e oferecer novas esperanças para pacientes que sofrem com essas condições.
Embora ainda esteja em estágio de desenvolvimento, a pesquisa sobre partículas imunomoduladoras já mostra resultados promissores. A comunidade científica aguarda com expectativa os resultados finais desses estudos, que podem levar a avanços significativos no combate a doenças virais e melhorar a qualidade de vida de milhões de pessoas em todo o mundo.